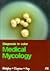
Medical Mycology, 1st, 1997...

Roderick J. Hay

|
Topley's and Wilson's Microbiology and Microbial Infections Vol. 3: Medical Mycology
by
—
published
1998
—
11 editions
|
|

|
Fortschritte in der lokalen antimykotischen Therapie
by
—
published
1988
—
2 editions
|
|

|
Imported Skin Diseases
by
—
published
2013
|
|

|
Topley & Wilson's Microbiology and Microbial Infections, Volume 4: Medical Mycology
by
—
published
1998
|
|
|
Medical Mycology, 1st, 1997, Mosby
by
—
published
2005
—
2 editions
|
|

|
Skin and Wound Infection: Investigation and Treatment in Practice
by
—
published
2000
—
3 editions
|
|

|
Onychomycosis/Les mycoses ungueales: Etapes diagnostique et clinique
by
—
published
1999
—
4 editions
|
|

|
Imported Skin Diseases
by
—
published
2007
—
5 editions
|
|
Is this you? Let us know. If not, help out and invite Roderick to Goodreads.



